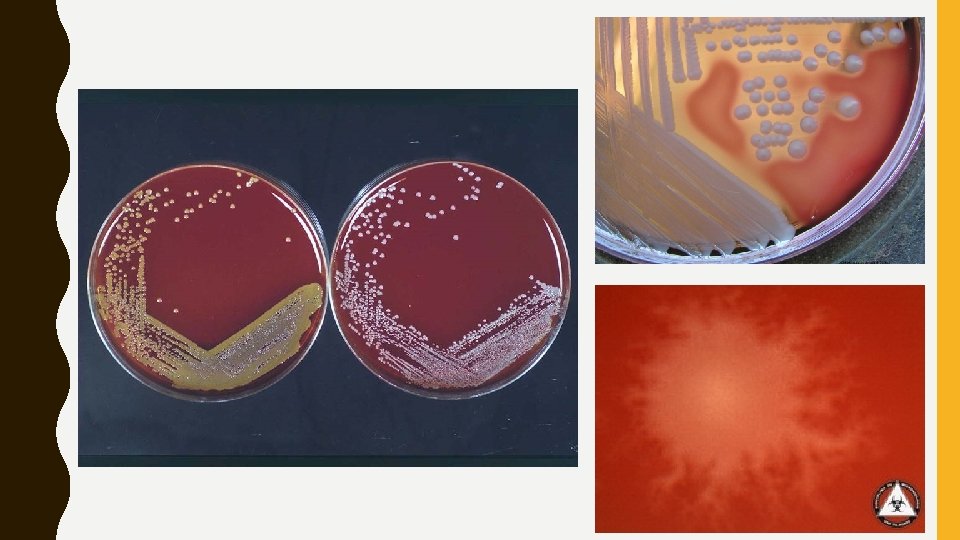
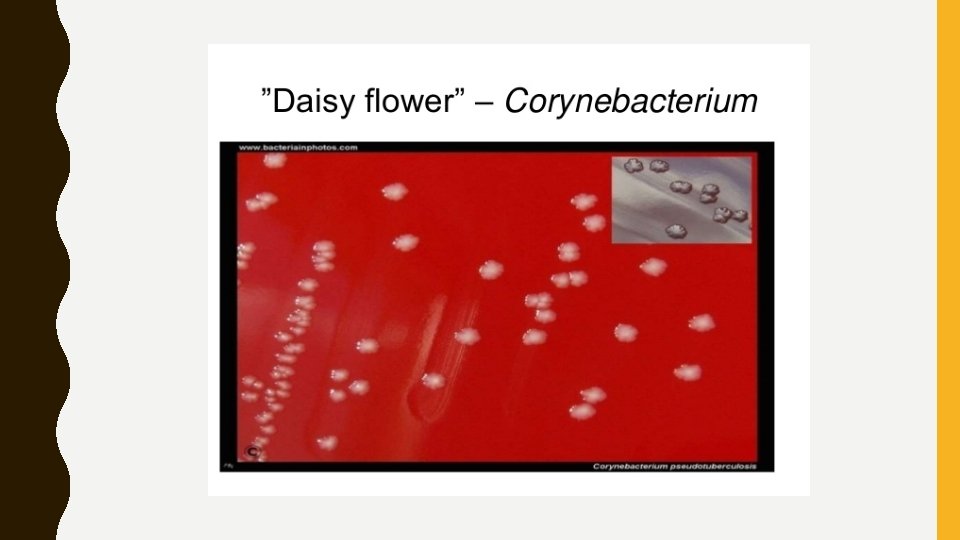
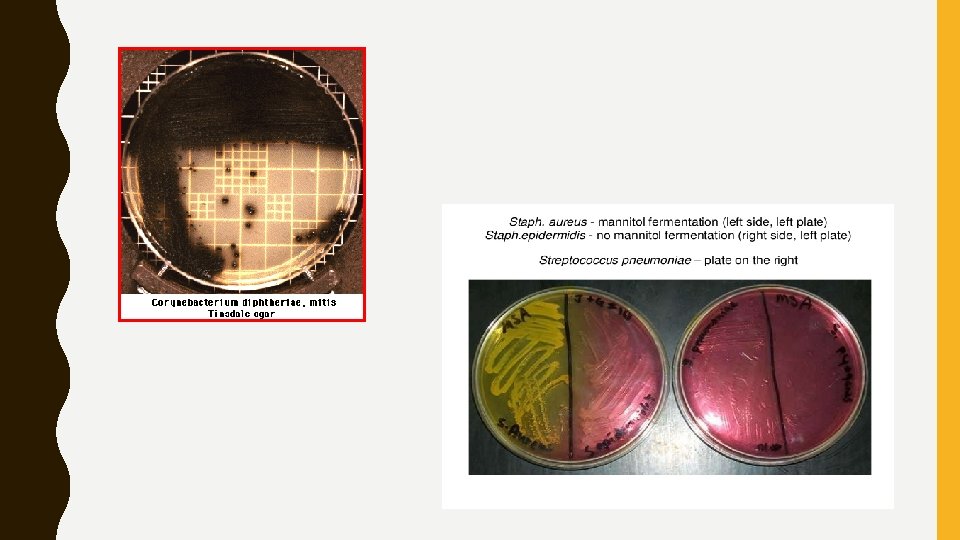
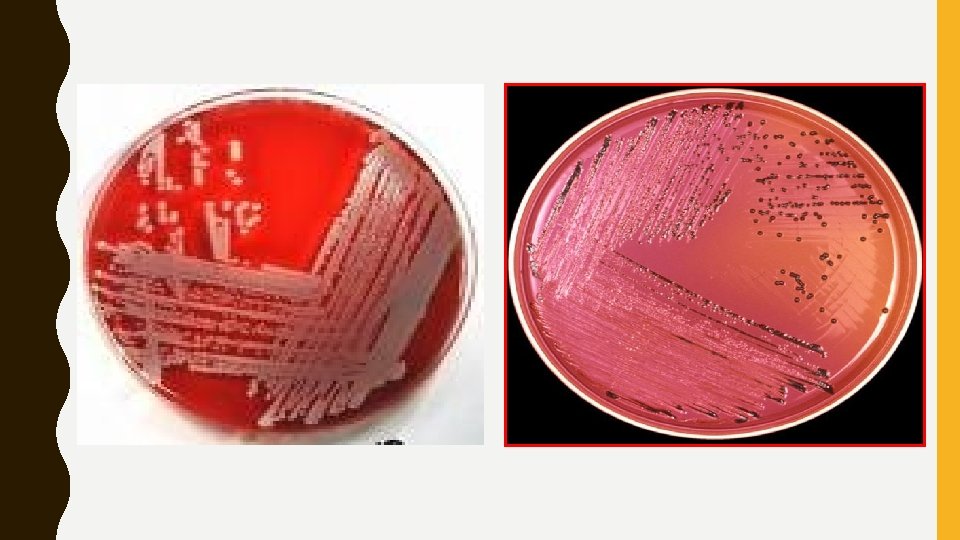
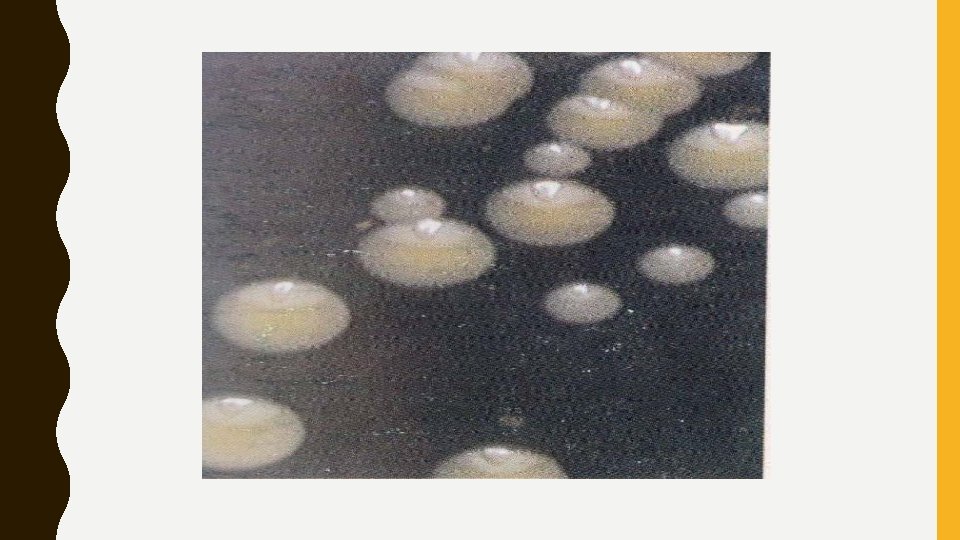

CARACTERE DE CULTUR NSM NAREA MEDIILOR DE CULTUR

- Slides: 51
CARACTERE DE CULTURĂ
ÎNSĂM NȚAREA MEDIILOR DE CULTURĂ Ø prin inoculare (inoculare prin epuizarea inoculului) Ø inoculare prin înțepare în toată coloana mediului Ø folosim ansa bacteriologică Ø inocularea în pânză: ü pipeta Pasteur (culturi lichide) ütampon îmbibat în cultură bacteriană
ÎNSĂM NȚAREA MEDIILOR DE CULTURĂ
INCUBAREA CULTURILOR Temperatura: 37˚C – majoritatea bacteriilor 20 -30˚C – Yersinia enterocolitica 42˚C – Campylobacter jejuni Atmosfera: oxigen-bacterii - aerobe - facultativ anaerobe CO 2 (5 -10%) bacterii carboxifile O 2+CO 2+N 2 bacterii microaerofile
FAZELE CREȘTERII BACTERIENE
CONDIȚII NECESARE 1. PH: - optim = 7 - majoritatea bacteriilor cresc între 6. 5 și 7. 5 - clasificare: - acidofile (cresc la p. H între 0. 1 și 5. 4) - neutrofile (p. H 5. 4 -8. 0) - bazofile (p. H 7. 0 -11. 0)
CONDIȚII NECESARE
CONDIȚII NECESARE
INCUBAREA CULTURILOR Atmosfera de CO 2
CONDIȚII DE ANAEROBIOZĂ
INCUBAREA CULTURILOR În mediul anaerob: 1. procedee chimice: - bulioane cu ingrediente reducătoare *acid thioglicolic *thioglicolat de Na - tehnica OTT – incinta etanșă (ulei de parafină) în care oxigenul este îndepărtat prin reacția cu pirogalolul în mediu alcalin 2. procedee biologice: - procedeul Tarozzi – tuburi cu bulion nutritiv în care agentul reducător sunt fragmentele de organe proaspete de animal prelevate aseptic (ficat, rinichi). - geloza Veillon (semisolid) – însămânțare prin încorporare în profunzime
CARACTERE DE CULTURĂ 1. Exigențe de cultivare bacterii nepretențioase Ø bacterii cu anumite exigențe nutritive Ø ü strict aerobe ü strict anaerobe ü facultativ anaerobe ü microaerofile ü carboxifile
CARACTERE DE CULTURĂ
CARACTERE DE CULTURĂ 2. Intervalul necesar pentru apariția culturii: Ø microorganisme cu creștere rapidă ü se dezvoltă în 18 -24 h Ø microorganisme cu creștere lentă ü necesită zile sau săptămâni
CARACTERE DE CULTURĂ 3. Morfologia coloniilor: a. dimensiunea: Ø mici (sub 1 mm diametru) Ø mijlocii Ø mari (peste 2 mm diametru) Ø microcolonii (stereomicroscop) b. forma: Ø punctiforme Ø circulare Ø neregulate (harta geografică) Ø filamentoase Ø dendritice Ø lenticulare
FORMA ȘI MĂRIMEA COLONIILOR Salmonella
CARACTERE DE CULTURĂ c. relieful: Ø Ø d. marginile: Ø Ø Ø plane aplatizate convexe bombate întregi ondulate lobate zimțate filamentoase cu valuri succesive de invadare
CARACTERE DE CULTURĂ e. suprafața Ø netedă, umedă, lucioasă (hidrofilie crescută) forma de cultură S Ø mată, uscată, rugoasă forma de cultură R Ø alte aspecte (papilată, striuri radiare, pufoasă, catifelată, zbârcită, lânoasă, prăfoasă)
CARACTERE DE CULTURĂ TIP S
CARACTERE DE CULTURĂ TIP M KLEBSIELLA Colonii mucoase
CARACTERE DE CULTURĂ TIP R Mycobacterium tuberculosis pe mediul Löwenstein Yensen Aspect conopidiform
CARACTERE DE CULTURĂ TIP R Bacillus anthracis Agar cromogenic Geloză sânge Geloză simplă
CARACTERE DE CULTURĂ TIP R Mediul Tinsdale Geloză sânge Corynebacterium diphteriae Aspect de margaretă
CARACTERE DE CULTURĂ f. densitatea optică: Ø colonii transparente Ø colonii semitransparente Ø colonii opace g. culoarea (pigmenți/indicatori) Ø albă Ø galbenă Ø aurie Ø neagră
CARACTERE DE CULTURĂ h. consistența - untoasă - mucoasă/filantă - albușului de ou bine bătut cu spumă - friabilă - cretoasă - pâsloasă - pieloasă
CARACTERE DE CULTURĂ 4. Modificări ale mediului: a. hemoliză pe agar sânge b. reacții pe medii diferențiale zaharate c. reacții pe mediul cu gălbenuș de ou d. pigmentogeneza Pot fi produse de citotoxine, enzime sau pigmenți difuzibili.
MODIFICĂRI ALE MEDIULUI HEMOLIZA PE GELOZA S NGE ü alfa: zona de înverzire a mediului cu numeroase hematii intacte din cauza hemolizei parțiale ü beta: zona complet clară, incoloră, din cauza hemolizei complete ü alfa – prim: halou de hemoliză incompletă cu înverzire, imediat înconjurat cu o zonă de hemoliză clară, completă ü gamma: absența hemolizei ü cald – rece: zona clară de hemoliză completă înconjurată de o zonă de hemoliză mai puțin clară, incompleta ( 37⁰ C / 4 ⁰C ).
MODIFICĂRI ALE MEDIULUI HEMOLIZA PE GELOZA S NGE Stafilococ Streptococ
MODIFICĂRI ALE MEDIULUI REACȚII PE MEDII DIFERENȚIALE ZAHARATE üViraj de culoare a mediului üCuloarea coloniilor în funcție de indicatorii de p. H üFermentarea / Nefermentarea substratului
MODIFICĂRI ALE MEDIULUI REACȚII PE MEDII DIFERENȚIALE ZAHARATE
MEDII DE CULTURĂ CU LACTOZĂ 1. LEVINE 2. DRIGALSKI 3. Mc. CONKEY ATENȚIE!! BACILI GRAM NEGATIVI: 1. ESCHERICHIA 2. SALMONELLA 3. SHIGELLA 4. KLEBSIELLA 5. PROTEUS Doar E. coli fermentează lactoza, deci este LACTOZO POZITIVĂ
MODIFICĂRI ALE MEDIULUI REACȚII PE MEDII CU GĂLBENUȘ DE OU üLecitinaza – precipitat opac în jurul coloniilor üLipaza – film circular cu irizație perlată în imediata vecinătate a coloniilor üProteoliza – clarificarea mediului din jurul coloniilor
MODIFICĂRI ALE MEDIULUI PIGMENTOGENEZA Pigmenți hidrosolubili difuzează și colorează progresiv mediul: ü Fluoresceina ü Piocianina ü Melanina
MODIFICĂRI ALE MEDIULUI PIGMENTOGENEZA Staphylococcus aureus pe mediul Chapman E. coli pe mediul Levine
CARACTERE DE CULTURĂ 5. Mirosul degajat de cultură: Ø flori de iasomie (Pseudomonas aeruginosa) Ø ciocolată arsă (Proteus) Ø putrid, fecaloid (Clostridium) Ø acru (Prevotella melaninogenica) Ø varză stricată (Citrobacter) Øsubsol mucegăit (Nocardia)
CARACTERE DE CULTURĂ 6. Aderența: Ø neaderente Ø puțin aderente Ø încastrate în mediu
MEDII LICHIDE Ø Turbiditatea Ø Sedimentul Ø Pelicula Ø Culoarea Ø Mirosul
MEDII LICHIDE Ø Tulburare uniformă a mediului (E. coli) Ø Tulburare+peliculă de suprafață (Piocianic) Ø Mediu limpede+peliculă (b. cărbunos) Ø Grunji (Streptococcus β hemoliticus)
MEDII LICHIDE
MEDII SOLIDE COLONIA = ansamblu localizat, alcătuit din populație pură de bacterii
MEDII SOLIDE Ø Relieful Ø Suprafața Ø Conturul Ø Mărimea Ø Pigmentarea Ø Consistența Ø Aderența Ø Hemoliza
VĂ MULȚUMESC!